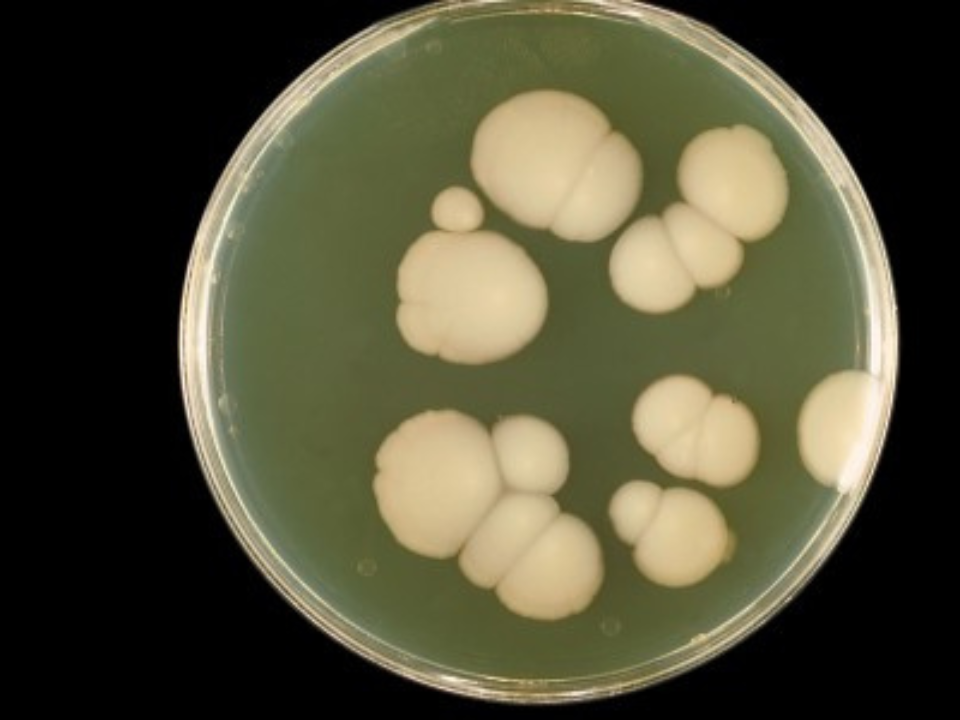
Terapia a laser potencializa tratamento contra fungo resistente a medicamento convencional

Pesquisadores do Centro de Pesquisa em Óptica e Fotônica (CePOF) conseguiram, por meio de uma terapia ativada por luz, aumentar a suscetibilidade do fungo Candida albicans à ação de medicamentos. Os resultados do estudo oferecem uma alternativa promissora no combate à resistência antimicrobiana – problema crescente no mundo que ocorre quando bactérias, vírus, fungos e outros parasitas desenvolvem mutações genéticas que os tornam resistentes aos efeitos dos medicamentos.
No estudo publicado na revista Photochemistry and Photobiology, os pesquisadores avaliaram a técnica de inativação fotodinâmica (PDI, na sigla em inglês para photodynamic inactivation) combinada com o antifúngico anfotericina B (AmB) para o controle do crescimento do fungo, especialmente nas formas de leveduras (células solitárias) e hifas (colônias filamentosas).
Os resultados demonstraram que a combinação dos dois tratamentos reduziu o crescimento do C. albicans, atingindo uma diminuição de 75% na forma de levedura e 87,5% na de hifa. Além disso, duas sessões de PDI aumentaram ainda mais a eficácia antifúngica, principalmente contra as hifas, que demonstraram maior sensibilidade ao tratamento.
“É uma técnica que consiste em utilizar uma molécula [neste caso a curcumina] e ativá-la com uma luz azul. A ativação, na presença de oxigênio, faz com que a molécula produza radicais livres e com isso induz o estresse oxidativo, matando ou enfraquecendo o patógeno”, explica Vanderlei Bagnato, coordenador do CePOF, um Centro de Pesquisa, Inovação e Difusão (CEPID) da FAPESP sediado no Instituto de Física de São Carlos da Universidade de São Paulo (IFSC-USP). “No caso do C. albicans, principalmente nas hifas, que formam um biofilme quase impenetrável para os medicamentos, a terapia fotodinâmica conseguiu ‘quebrar’ essas colônias, o que resultou na potencialização do efeito do antifúngico.”
No estudo, a inativação fotodinâmica foi realizada com curcumina – 2.5 μM (micrômetros) – ativada por aplicações de luz LED de 450 nm (nanômetros) e diferentes concentrações do antifúngico AmB.

Um perigo iminente
O C. albicans está naturalmente presente no organismo humano, sendo na maioria das vezes inofensivo. No entanto, podem ocorrer manifestações cutâneas como o sapinho ou a candidíase vaginal. Em alguns casos mais preocupantes, o fungo ocasiona a candidíase sistêmica, uma infecção invasiva do sangue. Essa condição grave tem sido diagnosticada com frequência crescente em Unidades de Terapia Intensiva (UTIs), por causa do aumento do número de pacientes imunocomprometidos e do aumento da resistência microbiana.
“Está ocorrendo uma resistência crescente dos fungos e o C. albicans não está fora desse processo. É um fungo muito comum, mas já existem casos de pacientes que morreram por causa de infecções sistêmicas resistentes. Por isso, é muito importante se antecipar ao problema e apresentar uma alternativa que permite um combate mais efetivo ao fungo, sem efeitos colaterais ou a necessidade de um uso exagerado de medicamentos”, afirma Gabriela Gomes Guimarães, pesquisadora do CePOF e primeira autora do estudo.
Guimarães explica que a decisão de começar os testes de inativação fotodinâmica em fungos pelo C. albicans foi motivada pelas duas morfologias da espécie. “O fungo forma tanto leveduras quanto hifas, sendo que no caso das hifas elas formam os biofilmes. Portanto, o fato de ter funcionado tão bem para C. albicans nos dá segurança de realizar novos testes em outras espécies, como C.auris, um fungo emergente, preocupante, que tem apresentado resistência a tratamentos e pode ser fatal”, conta a pesquisadora.
Aplicações em alimentos
Além de testar os efeitos da terapia fotodinâmica em outras espécies de fungos que representem uma ameaça à saúde humana, os pesquisadores também vão realizar estudos voltados para a segurança alimentar. “A prova de princípio que acabamos de publicar sobre C. albicans nos permite realizar estudos para a aplicação da terapia fotodinâmica na descontaminação de alimentos. Os fungos também são um problema na contaminação de grãos, por exemplo. Portanto, nosso próximo passo é testar a aplicação dessa técnica em silos de armazenamento, por exemplo”, antecipa Bagnato.
O CePOF tem desenvolvido diversas pesquisas com laser com o objetivo de impulsionar tratamentos contra bactérias, vírus e outras doenças, entre elas o câncer e a fibromialgia (leia mais em: agencia.fapesp.br/51784).
“O princípio é sempre o mesmo: ativar uma molécula com um laser para que ela oxide. O que varia para cada caso é a aplicação, a quantidade de luz, temperatura de cor, quantidade de droga e quanto do patógeno é eliminado ou inativado”, resume Bagnato.
Jennifer Soares, integrante do CePOF e bolsista da FAPESP, explica que outra preocupação dos pesquisadores é utilizar moléculas compatíveis com a saúde humana e o meio ambiente.
“A curcumina, por exemplo, é um composto presente no curry e já tem aprovação para aplicação em humanos. Mas há também um cuidado sobre como realizar a aplicação da luz. Nossos estudos têm mostrado que a luz azul, em razão do seu comprimento de onda, é ideal para tratar infecções superficiais como a da garganta. Por isso, estamos desenvolvendo dispositivos capazes de iluminar as amígdalas, por exemplo. Já a luz vermelha ou infravermelha é mais indicada para tratar infecções profundas, como pneumonia, o que exige dispositivos adaptados para iluminar a região torácica”, explica.
O CePOF realiza também estudos voltados ao tratamento de câncer do colo uterino, permitindo a aplicação da medicação e das moléculas fotossensibilizadoras por vias específicas, como o canal intravaginal.
O artigo Overcoming resistance of Candida albicans using photodynamic inactivation pode ser lido em: https://onlinelibrary.wiley.com/doi/full/10.1111/php.14108.
Matéria – Maria Fernanda Ziegler | Agência FAPESP
Imagem – Combinação de inativação fotodinâmica com anfotericina B combateu com sucesso o fungo Candida albicans, obtendo redução de 75% em sua forma de levedura e 87,5% na de hifa (imagem: Wikipedia)